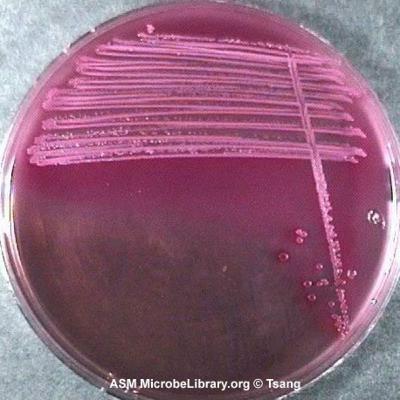

Protein Synthesis Part 2 Tropp Chapter 16
Update: 2024-08-17
Description
Summary videos: https://www.youtube.com/watch?v=5bLEDd-PSTQ https://www.youtube.com/watch?v=Ikq9AcBcohA
Kirky Stanford video: https://library.ucsd.edu/dc/object/bb90484996 (best quality video)
and a story of its making: https://stanmed.stanford.edu/protein-synthesis-an-epic-on-the-cellular-level/
Comments
In Channel